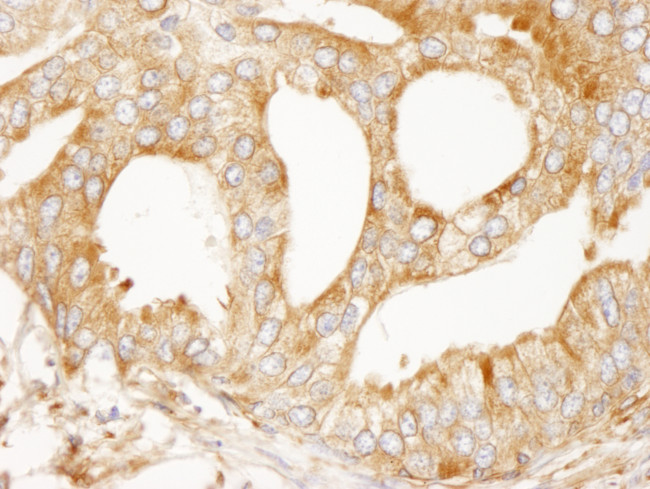
MAP4 Antibody in Immunohistochemistry (Paraffin) (IHC (P))

Search
Bethyl Laboratories
MAP4 Polyclonal Antibody
{{$productOrderCtrl.translations['antibody.pdp.commerceCard.promotion.promotions']}}
{{$productOrderCtrl.translations['antibody.pdp.commerceCard.promotion.viewpromo']}}
{{$productOrderCtrl.translations['antibody.pdp.commerceCard.promotion.promocode']}}: {{promo.promoCode}} {{promo.promoTitle}} {{promo.promoDescription}}. {{$productOrderCtrl.translations['antibody.pdp.commerceCard.promotion.learnmore']}}
产品信息
IHC-00532
种属反应
宿主/亚型
分类
类型
抗原
偶联物
形式
浓度
规格
纯化类型
保存液
内含物
保存条件
运输条件
产品详细信息
The recommended shelf life for this product is 1 year from date of receipt.
Based on 100% sequence identity, this antibody is predicted to react with Mouse, Rat, Horse, Cat, Orangutan, Monkey, Gorilla and Chimpanzee
靶标信息
The protein encoded by this gene is a major non-neuronal microtubule-associated protein. This protein contains a domain similar to the microtubule-binding domains of neuronal microtubule-associated protein (MAP2) and microtubule-associated protein tau (MAPT/TAU). This protein promotes microtubule assembly, and has been shown to counteract destabilization of interphase microtubule catastrophe promotion. Cyclin B was found to interact with this protein, which targets cell division cycle 2 (CDC2) kinase to microtubules. The phosphorylation of this protein affects microtubule properties and cell cycle progression. Multiple transcript variants encoding different isoforms have been found for this gene. [provided by RefSeq].
仅用于科研。不用于诊断过程。未经明确授权不得转售。
篇参考文献 (0)
生物信息学
蛋白别名: MAP-4; Microtubule-associated protein 4; unnamed protein product
基因别名: MAP4
UniProt ID: (Human) P27816
Entrez Gene ID: (Human) 4134